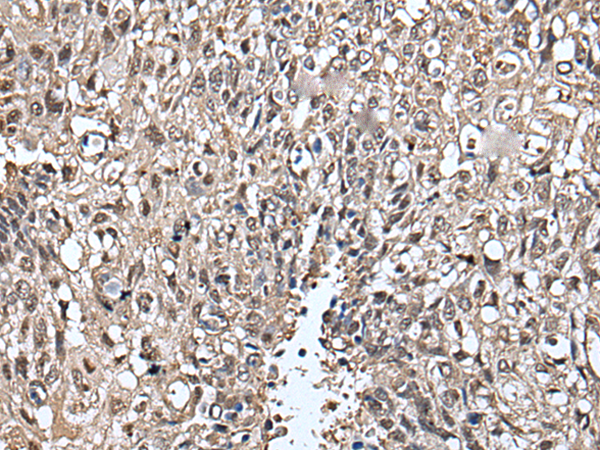

|
Background: |
Members of the SLITRK family, such as SLITRK5, are integral membrane proteins with 2 N-terminal leucine-rich repeat (LRR) domains similar to those of SLIT proteins (see SLIT1; MIM 603742). Most SLITRKs, including SLITRK5, also have C-terminal regions that share homology with neurotrophin receptors (see NTRK1; MIM 191315). SLITRKs are expressed predominantly in neural tissues and have neurite-modulating activity (Aruga et al., 2003 [PubMed 14557068]). |
|
Applications: |
ELISA, IHC |
|
Name of antibody: |
SLITRK5 |
|
Immunogen: |
Fusion protein of human SLITRK5 |
|
Full name: |
SLIT and NTRK like family member 5 |
|
Synonyms: |
LRRC11; bA364G4.2 |
|
SwissProt: |
O94991 |
|
ELISA Recommended dilution: |
5000-10000 |
|
IHC positive control: |
Human lung cancer and human prostate cancer |
|
IHC Recommend dilution: |
25-100 |

購物車
購物車 幫助
幫助
 021-54845833/15800441009
021-54845833/15800441009
